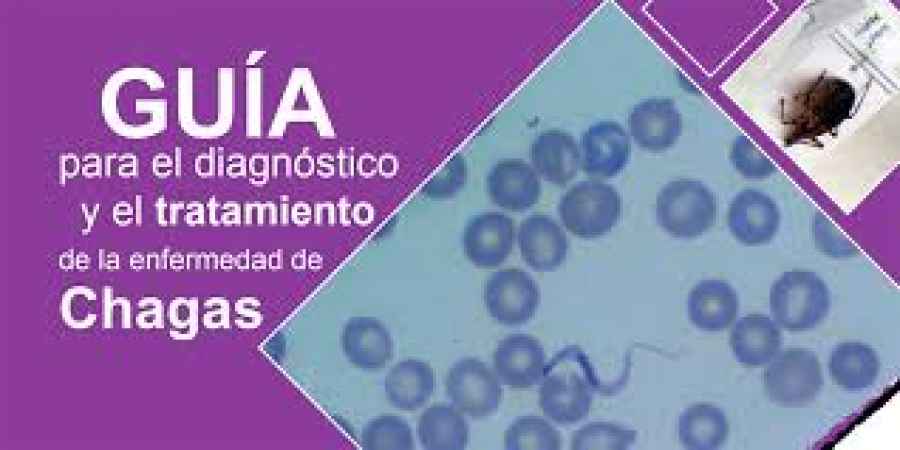
OPS lanza nueva gu&iacute;a para el diagn&oacute;stico y tratamiento del Chagas

Mostrando artículos por etiqueta: Chagas
Primera formulación pediátrica de medicamento para el chagas
El grupo de Parasitología – Chagas, del Instituto Multidisciplinario de Investigación en Patologías Pediátricas (IMIPP, CONICET-Gobierno de la Ciudad de Buenos Aires), en el Hospital de Niños ‘Ricardo Gutiérrez’, coordinó los estudios clínicos de una formulación pediátrica, inédita, de un medicamento utilizado en el tratamiento de la enfermedad de Chagas -el nifurtimox-, que se adapta a las necesidades especiales de los pacientes pediátricos desde recién nacidos hasta los 18 años de edad.
Los resultados sobre la formulación pediátrica esta droga, una de los dos desarrolladas hace 5 décadas para el uso en la enfermedad en adultos, resultaron en la aprobación por la Administración de Alimentos y Drogas de los Estados Unidos (FDA, por sus siglas en inglés), por lo que a nivel local estará de manera expeditiva aprobado su uso por ANMAT.
“Este es un gran logro de la pediatría argentina y latinoamericana, que a partir de una red de investigación clínica con altos estándares de calidad, obtuvo respuesta a una necesidad regional que impactará en la atención de los más vulnerables”, consideró el Dr, Jaime Altcheh pediatra e investigador principal del CONICET, quien lidera el equipo de trabajo.
Utilizar, como hasta el momento, las presentaciones de adultos y adaptarlas a los niños conlleva un problema, y es que cuando se fraccionan las pastillas, no puede asegurarse que la concentración de la droga es la misma en cada parte. Esto genera el riesgo de dar menores o mayores dosis a las necesarias. “El desarrollo y validación, en estudios clínicos, de una formulación dispersable adaptada para niños resuelve este problema y facilitara el tratamiento”, aclara el investigador.
El estudio se llevó a cabo en 25 sitios de investigación, que conforman la Red de Investigación Clínica PEDCHAGAS, en Argentina, Bolivia, y Colombia entre 2016 y 2018, en conjunto con el laboratorio Bayer. Se trató de un ensayo clínico de fase III prospectivo, donde se evaluó la eficacia, seguridad y farmacocinética de nifurtimox en 330 niños con enfermedad de Chagas.
“A pesar de estar aprobados para su uso en adultos desde la década del 70, es la primera vez que se hace un estudio farmacológico multicéntrico en pacientes pediátricos de este medicamento”, explica Altcheh.
Enfermedad de Chagas
El Chagas es una enfermedad causada por el parásito Trypanosoma cruzi, que transmite hacia el humano la vinchuca -Triatoma infestans-. También puede ser contagiado por transfusión sanguínea o trasplante de órganos, y durante la gestación, o por alimentos. Según datos publicados por la OMS, se calcula que en el mundo existen entre 6 a 7 millones de infectados, y en la Argentina, según estimaciones de la Sociedad Argentina de Pediatría, nacen 1200 niños con la enfermedad.
La crisis venezolana dispara enfermedades como la malaria, el dengue y chagas
El colapso en la atención de la salud y la drástica disminución de programas de salud pública son culpables directos de que el primer país que logró el certificado de la OMS por erradicar la malaria en 1961 haya registrado durante 2017 un total de 411.586 casos. El resurgimiento de una enfermedad que “pronto podría convertirse en incontrolable”, según señala una revisión que acaba de publicar la revista The Lancet Infectious Diseases. Malaria, Chagas, chikungunya, dengue o el virus del Zika… La crítica situación que vive Venezuela está acelerando la reaparición de enfermedades transmitidas por vectores (insectos como los mosquitos y las garrapatas) y amenaza con poner en riesgo la salud pública del país. Dichas afecciones van conquistando cada vez más territorios del país, incluso se extienden más allá, especialmente a Brasil y Colombia. De acuerdo con los datos del Ministerio de Sanidad de Brasil, en 2016, el 45% de los casos de malaria del municipio brasileño de Paracaima y el 86% de los registrados en Boa Vista fueron atribuidos a la inmigración venezolana. Se calcula que entre 2014 y 2018, 1,5 millones de venezolanos abandonaron su país para irse a vivir a otra nación de América Latina o a otra región del Caribe. En 2018, el promedio de personas que dejan Venezuela todos los días se sitúa en 5.500. Tras el análisis de toda la información recabada, los autores concluyeron que entre 2010 (29.736) y 2015 (136.402), Venezuela experimentó un aumento del 359% en casos de malaria, seguido del incremento del 71% entre 2016 (240.613) y 2017 (411.586). “Es potencialmente el mayor aumento de malaria reportado en todo el mundo”, dicen los responsables del trabajo. “La cruda realidad es que en ausencia de medidas de vigilancia, diagnóstico y prevención, estas cifras probablemente representan una subestimación de la situación real”, afirma Martin Llewellyn, líder de la revisión y profesor de la Universidad de Glasgow, Reino Unido.También llama la atención el capítulo dedicado a la enfermedad de Chagas, una de las principales causas de insuficiencia cardiaca en América Latina. Según las muestras recogidas entre 2008 y 2018, la seroprevalencia en niños menores de 10 años se estimó en 12,5% en algunas comunidades, en comparación con un mínimo histórico del 0,5% en 1998. Resultados lógicos teniendo en cuenta que “desde 2012, la vigilancia y el control de esta enfermedad han sido abandonados en Venezuela”, puntualiza Llewellyn. En cuanto al dengue, se ha multiplicado por cinco, con una incidencia promedio de 211 casos por cada 100.000 personas entre 2010 y 2016 y seis epidemias cada vez más grandes registradas a nivel nacional entre 2007 y 2016.El potencial epidémico de la fiebre chikungunya parece estar subiendo peldaños también. Se estima que en 2014 hubo dos millones de casos sospechosos. Lo que está claro es que la agitación social, política y económica que los venezolanos llevan soportando la última década deja a su país en crisis, “con capacidad reducida para una intervención efectiva”. Afortunadamente, los autores ven posibles soluciones, incluso con recursos restringidos. Un buen ejemplo, apunta Llewellyn, es la estrategia binacional para la eliminación de la malaria en la frontera entre Perú y Ecuador. Mantienen una estrecha colaboración en la vigilancia y la formación del personal para recoger muestras de personas febriles dentro de sus comunidades fronterizas, lo que impulsa un diagnóstico y tratamiento eficaces. También intercambian recursos tales como información, medicamentos e insecticidas. El gran desafío es identificar y evaluar a las personas con más probabilidades de infección. Por eso, comentan los autores, es especialmente importante que las comunidades con mayor riesgo de enfermedad estén informadas sobre la creciente amenaza. Los expertos señalan, además, que la vigilancia es crucial y se debe utilizar para crear conciencia entre las autoridades venezolanas y regionales, y alentarlos a reconocer la creciente crisis, cooperar y aceptar intervenciones médicas internacionales. “Pedimos a los miembros de la Organización de los Estados Americanos y otros organismos políticos internacionales que presionen más al gobierno venezolano para que acepte la asistencia humanitaria ofrecida por la comunidad internacional para fortalecer el sistema de salud. Sin tales esfuerzos, los avances en salud pública logrados en los últimos 18 años podrían revertirse pronto”, advierte Llewellyn.
Fuente: Consenso salud
OPS lanza nueva guía para el diagnóstico y tratamiento del Chagas
OPS) Alrededor de 65 millones de personas viven en riesgo de contraer Chagas en 21 países endémicos de las Américas, una infección parasitaria que se cobra cada año a unas 12.000 vidas en la región. Para mejorar la detección y el manejo clínico de los nuevos casos, la Organización Panamericana de la Salud (OPS) lanzó una nueva Guía para el diagnóstico y tratamiento de la enfermedad de Chagas.
El Chagas o tripanosomiasis americana es una parasitosis endémica que puede transmitirse a través de insectos – conocidos como vinchucas, chinches o chirimachas-, transfusión, vía transplacentaria o por alimentos. Más de 6 millones de personas viven con la enfermedad en las Américas, en su mayoría sin saberlo. Además, se estima que se producen 28.000 nuevos casos cada año por transmisión vectorial, y otros 8.000 casos por transmisión congénita.
Todas estas características hacen de la enfermedad de Chagas una patología regional con impacto negativo en salud pública y con potencial dispersión a otros continentes a través de su transmisión congénita y sanguínea.
Sin embargo, el personal de salud en la Región se mantiene y trabaja con poca información, así como con capacitación mínima, por lo que la guía busca fortalecer sus capacidades para un diagnóstico y tratamiento oportunos y adecuados, incluyendo un manejo clínico integral.
El material apunta también a establecer procedimientos más claros y estandarizados para proveer una mejor atención y asistencia en los servicios de salud a cada persona infectada por esta enfermedad parasitaria potencialmente mortal causada por el Trypanosoma cruzi, algo que contribuirá, además, a la mejora de la salud de los pacientes, sus familias y sus comunidades.
La nueva guía, desarrollada por expertos en el tema, contiene conocimiento basado en la evidencia, a través de la metodología GRADE (Grading of Recommendations Assessment, Development and Evaluation, por sus siglas en inglés), de manera que aporta una síntesis de la evidencia actualmente conocida y publicada sobre el tema.
— Para acceder a la guía ingrese a este enlace
Fuente: Consenso Salud
Científicos argentinos avanzan en una vacuna contra el Chagas
Científicos del CONICET diseñaron un nuevo prototipo de vacuna contra el parásito causante de la Enfermedad de Chagas que podría adaptarse en un futuro a otras patologías. Los resultados fueron publicados en la revista Frontiers in MIcrobiology.
Una investigación, muchas voces
“Nuestro trabajo tiene un diseño original. El prototipo de vacuna sobre la que trabajamos es de tipo oral y utiliza una bacteria no patógena apta para el consumo humano, Lactococcus lactis, que se encuentra y se utiliza en la producción de quesos y otros derivados lácteos. Además, el prototipo de la vacuna es un modelo de estudio genético y biotecnológico que permite la producción de distintos biofármacos, como hormonas, interferón o antígenos. En este momento muchas vacunas de este estilo se encuentran en etapa de diseño y experimentación y se espera la aprobación de algunas de ellas para los próximos años”, señala Christian Magni, investigador principal del CONICET en el Instituto de Biología Molecular y Celular de Rosario (IBR, CONICET-UNR).
El investigador explica que una vacuna a subunidades está compuesta por un antígeno, que es el responsable de despertar la respuesta inmune del organismo y un adyuvante, cuya función es optimizarla. El prototipo diseñado se basa en la expresión por la bacteria L. Lactis de un fragmento de una proteína antigénica de Trypanosoma cruzi.
“Uno de los adyuvantes más utilizados en la producción de vacunas es el aluminio, sin embargo, nosotros utilizamos uno específico de mucosas que se encuentra en fase de experimentación, denominado AMP-di-cíclico. Este compuesto actúa normalmente como un segundo mensajero en L. lactis, por lo que en nuestro prototipo se logró incrementar los niveles de este compuesto a partir de la sobreexpresión de la enzima responsable de su síntesis”, explica.
El prototipo fue inicialmente evaluado en un sistema desdoblado, utilizando dos cepas de L. lactis: una capaz de producir el antígeno y otra del adyuvante. Posteriormente se construyó un sistema que reúne ambos componentes en un solo microorganismo. De esta forma, la vacuna experimental consistió en una bacteria L. lactis que expresa el antígeno de Tripanosoma cruzi, complementada por la producción de un adyuvante, la cual mostró tener buena capacidad inmunizante.
“Desde el punto de vista inmunológico la originalidad de este trabajo consiste en que a través de un sistema de delivery se puede transportar el antígeno y el adyuvante, que es lo que optimiza la respuesta inmune, en una sola bacteria”, indica Ana Rosa Pérez, investigadora independiente del Consejo en el Instituto de Inmunología Clínica y Experimental de Rosario (IDICER, CONICET-UNR).
Para saber si la vacuna generaba inmunidad, los investigadores administraron por vía oral a animales de experimentación las bacterias L. lactis que expresaban el antígeno y producían el adyuvante, y posteriormente realizaron distintas pruebas para comprobar si se había producido memoria inmunológica contra el antígeno del parásito. Los resultados encontrados fueron muy alentadores, ya que la vacuna produjo una buena respuesta celular y de anticuerpos.
Vías de administración de la vacuna
“Hoy se sabe que una respuesta inmune inducida a nivel de mucosas es también capaz de generar una respuesta sistémica. Este tipo de inmunizaciones tiene el potencial de controlar al patógeno independientemente de cuál sea su vía de entrada”, explica Pérez. Por otra parte, la administración de una vacuna por vía oral, evita la molestia y el dolor que suelen causar las inyecciones. Si bien, en particular, probamos este sistema de administración oral como una potencial vacuna contra T. cruzi, cambiando el antígeno podría utilizarse para cualquier patógeno contra el cual uno quisiera desarrollar una vacuna”, destaca la investigadora.
Avances
En el año 2013 el grupo de investigadores recibió el premio Sanofi-CONICET “Incentivo a la Innovación en Enfermedades Huérfanas” que permitió que avancen con el diseño del prototipo de esta vacuna oral contra la Enfermedad de Chagas, que incluso, podría a futuro adaptarse al diseño de vacunas administradas a nivel de mucosas contra otros patógenos.
“La utilización de proteínas obtenidas por tecnología recombinante para el diseño de vacunas requiere de la presencia de un adyuvante que mejore su respuesta inmune. Este prototipo facilita la producción in vivo del sistema antígeno/adyuvante y no requiere de pasos de purificación, ya que es el microorganismo que realiza la síntesis y el transporte de la vacuna. El uso de un microorganismo seguro para el consumo como lo es L. lactis, del cual se conoce su fisiología y su genética, permite el avance de este tipo de diseño”, aclara Magni.
“Hace años que se trabaja en vacunas para Chagas y todos los modelos y prototipos que se han probado producen buenos niveles de protección en animales de experimentación, pero no generan inmunidad esterilizante, es decir, la eliminación total del parásito. Quizás no debamos aspirar a eso, ya que, por ejemplo, la vacunacontra la malaria que está próxima a ser aceptada no genera inmunidad esterilizante, pero disminuye la cantidad de enfermos”, reflexiona Pérez.
El grupo actualmente está trabajando en dos frentes que abren futuros saberes: seguir profundizando su investigación en torno a la respuesta inmune protectora que genera su vacuna experimental y, por otro lado, evaluar el sistema de delivery que combine antígeno/adyuvante contra otros patógenos.
Ciencia colaborativa
“Es importante poder destacar y rescatar la forma colaborativa en la que se hizo este trabajo, en donde se logró la vinculación de la empresa Sanofi, la Universidad y CONICET”, asegura Magni. Esta forma de cooperación permite la resolución de un problema complejo, que requiere del tiempo, trabajo y esfuerzo de muchos investigadores, becarios y técnicos. En el 2013 nos preguntamos si podíamos diseñar nuevas vacunas a partir del conocimiento que teníamos. Transformamos esta idea en un diseño y obtuvimos resultados tendientes al desarrollo de conocimiento básico y aplicado. Estos proyectos deben ser continuados en el tiempo para lograr mejores resultados, y esto no siempre es fácil”, señala Magni.
Grupo de investigación:
Laboratorio de Fisiología y Genética de Bacterias Lácticas, Instituto de Biología Molecular y Celular de Rosario (IBR, CONICET- UNR); y Laboratorio de Biotecnología e Inocuidad de los Alimentos. FBioyF UNR – Municipalidad de Granadero Baigorria, Rosario, Argentina.
Christian Magni, Ingrid Quintana, Martín Espariz, Víctor Blancato.
Laboratorio de estudios en Enfermedad de Chagas, Instituto de Inmunología Clínica y Experimental de Rosario (IDICER, CONICET-UNR); y Centro de Investigación y Producción de Reactivos Biológicos (CIPReB), Facultad de Ciencias Médicas, Rosario, Argentina.
Ana Rosa Pérez, Florencia B. González, Florencia Pacini, Silvina Villar, Gustavo Chapo.
Laboratorio de Tecnología Inmunológica, Facultad de Bioquímica y Cs Biológicas, Universidad Nacional del Litoral, Santa Fe, Argentina y Facultad de Ciencias Médicas, Universidad Nacional del Litoral, Santa Fe, Argentina.
Iván Marcipar, Gabriel Cabrera, Iván Bontempi, Stefanía Procheto.
Fuente: Conicet
Se aprobó un medicamento para el tratamiento de la enfermedad de Chagas en población pediátrica
La Argentina aprueba presentación pediátrica del medicamento usado para el tratamiento de la enfermedad de Chagas. El benznidazol, que a partir de ahora estará también disponible en comprimidos de 12,5 mg, dosis requerida para atender a la población de 0 a 2 años, fue aprobado por la Administración Nacional de Medicamentos, Alimentos y Tecnología Médica (ANMAT).
Según la Organización Mundial de la Salud (OMS), el Chagas afecta a más de 6 millones de personas en el mundo, de las cuales más de 1,2 millones son mujeres en edad fértil. Todos los años casi 9.000 niños nacen con la enfermedad de Chagas por transmisión vertical (hijos de madres infectadas que contraen la enfermedad por vía transplacentaria). En Argentina, la población en riesgo de contraer Chagas es mayor a 7 millones de personas, mientras que más de 1,5 millones tienen la enfermedad.
La formulación pediátrica del benznidazol, de 12.5mg., empezó a desarrollarse en Argentina a partir de un acuerdo entre la Fundación Mundo Sano (FMS) y la Iniciativa Medicamentos para Enfermedades Olvidadas (DNDi, por sus siglas en inglés) en 2013 para garantizar el tratamiento de niños entre 0 y 2 años de edad.
El benznidazol fue incluido en el listado de medicamentos esenciales de la Organización Mundial de la Salud (OMS) y cuenta con registro sanitario en la mayoría de los países endémicos de América Latina, siendo Elea-Phoenix, laboratorio certificado por la OPS como el único productor global bajo buenas prácticas de manufactura (GMP, por sus siglas en ingles).
Esta enfermedad es uno de los mayores problemas de salud pública en América Latina y muy pocas personas con Chagas tienen acceso al tratamiento. Frente a esta realidad, la Fundación Mundo Sano y la Iniciativa Medicamentos para Enfermedades Olvidadas (DNDi, por sus siglas en inglés) se comprometieron a sumar esfuerzos para proveer acceso a los tratamientos contra la enfermedad de Chagas a los pacientes. “Las evidencias médicas demostrarán la eficacia del benznidazol en el tratamiento de la enfermedad de Chagas. Nuestro esfuerzo colectivo es de garantizar que los pacientes acedan al tratamiento existente, mientras seguimos con la búsqueda activa de nuevas herramientas de salud”, sostuvo Michel Lotrowska, director ejecutivo interino de
DNDi América Latina.
Chagas: importante aprobación
La Fundación Mundo Sano, Grupo Insud y Laboratorios Elea comunican que el 29 de agosto pasado la Administración de Alimentos y Fármacos de los Estados Unidos (FDA, por sus siglas en inglés) aprobó la solicitud de nuevo fármaco para el benznidazol del Grupo Chemo. Se trata del primer medicamento aprobado por la FDA para tratar la enfermedad de Chagas.
El benznidazol es un medicamento esencial para el tratamiento del Chagas, una peligrosa enfermedad parasitaria que afecta a un estimado de 6 a 8 millones de personas en el mundo, según la Organización Mundial de la Salud. La resolución de la FDA otorga la aprobación para el uso de benznidazol en niños de 2 a 12 años de edad, y se continuará trabajando en colaboración con la agencia sanitaria de ese país para expandir la indicación.
La historia de este logro comienza en la Argentina, hace varios años atrás, cuando el Ministerio de Salud decidió poner el Chagas en agenda. A inicios del 2011, cuando como consecuencia de que la Argentina y el mundo ya no dispondrían de medicamentos para tratar la enfermedad, el Ministerio de Salud convocó a la industria farmacéutica para pedir que se ocuparan de producir el medicamento. Fue entonces que la Fundación Mundo Sano asumió el riesgo y la responsabilidad de concretar, en un tiempo récord, la fabricación de benznidazol bajo normas de Buenas Prácticas de Manufactura (GMP, por sus siglas en inglés), para que el medicamento estuviera disponible.
Maprimed, la planta química del grupo Roemmers y de INSUD, y Química Sintética, planta química en España de grupo INSUD colaboraron con la producción del principio activo; mientras que Elea se encargó de la fabricación del medicamento. Los datos clínicos fueron aportes de los médicos argentinos referentes en Chagas y se sumó el compromiso de la autoridad sanitaria local (ANMAT) para acelerar el procedimiento de aprobación.
Abarax (Benznidazol) de Laboratorios Elea fue aprobado en febrero de 2012 y, en marzo, se entregó el primer lote al Ministerio de Salud y a Mundo Sano. En 2013, la Organización Mundial de la Salud incorporó el benznidazol al Listado de Medicamentos Esenciales.
Actualmente, ese tratamiento cuenta con registro en Argentina, Bolivia, Paraguay, Chile, Honduras, Guatemala y México y fue autorizado a distribuirse por las agencias sanitarias en España, Italia, Suiza, Australia y Canadá. Además, a través del Fondo Estratégico de la Organización Panamericana de la Salud se ha enviado a Venezuela, Bolivia, Colombia y Panamá.
Lo más visto
- Covishield, la vacuna que India lanzó con Oxford-AstraZeneca
- El gobierno establece los requisitos para la producción de cannabis medicinal
- Anmat aprobó en el país la primera vacuna que protege contra el dengue
- Comunicación de Novo Nordisk: Diferencias en la indicación de Victoza® y Saxenda®
- Ibupirac declarado apto para celíacos